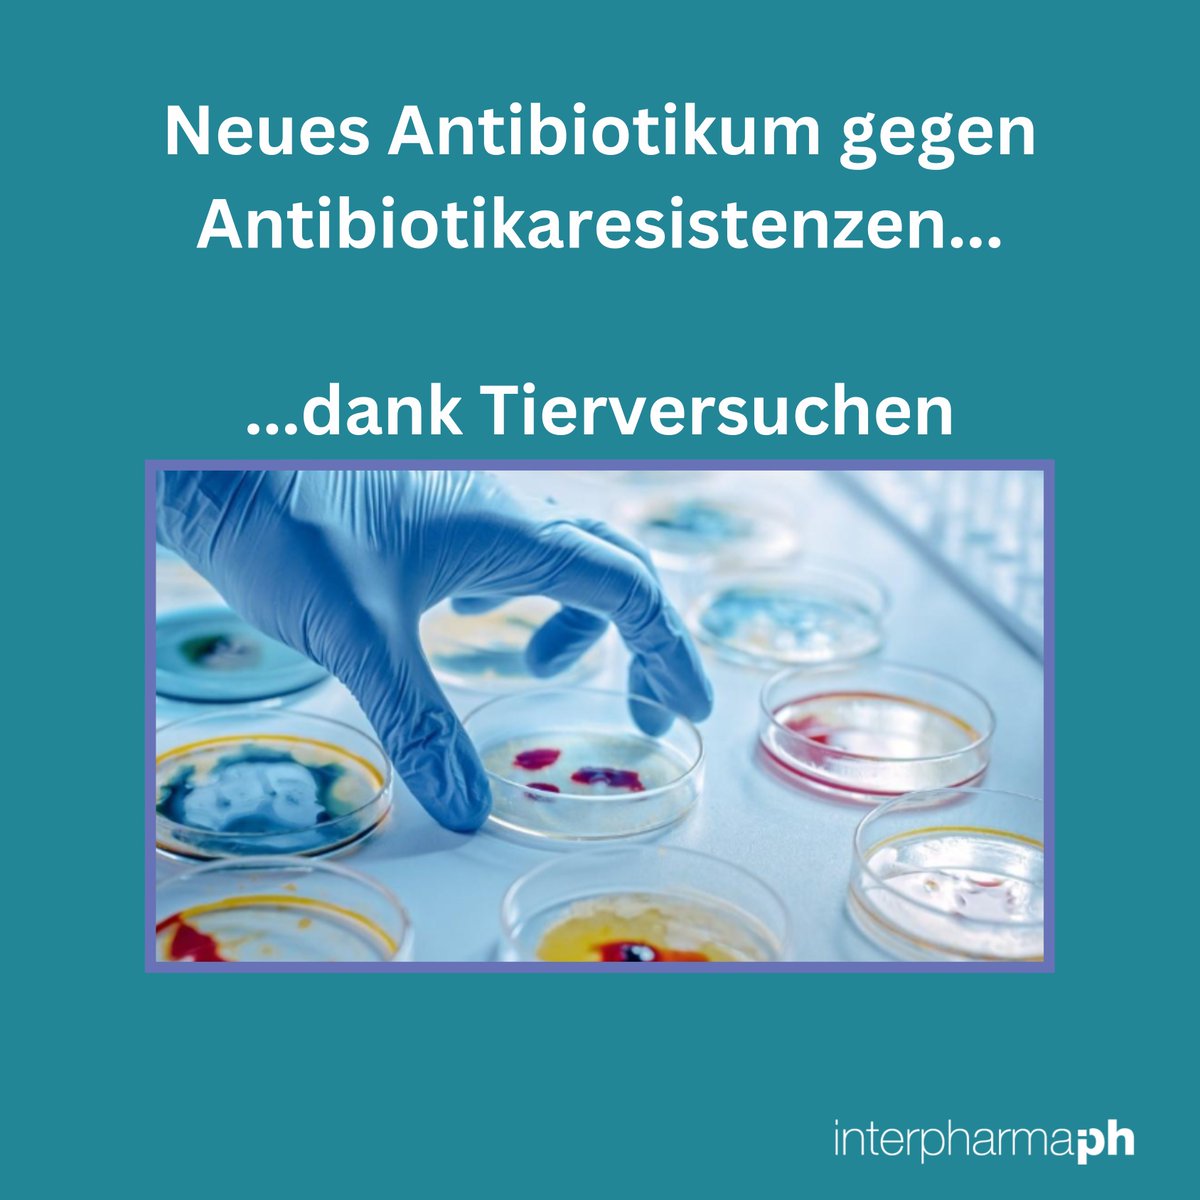
Interpharma tweet media

Sabitlenmiş Tweet

Wir stehen am Wendepunkt: Die medizinische Spitzenversorgung in der Schweiz erodiert. An der Jahres-Medienkonferenz von Interpharma wurde klar: 2026 entscheidet sich, ob wir Stillstand akzeptieren oder Fortschritt sichern. Politik und Industrie müssen jetzt gemeinsam handeln, damit die Schweiz führender #Pharmastandort bleibt.
interpharma.ch/blog/schweizer…

Deutsch